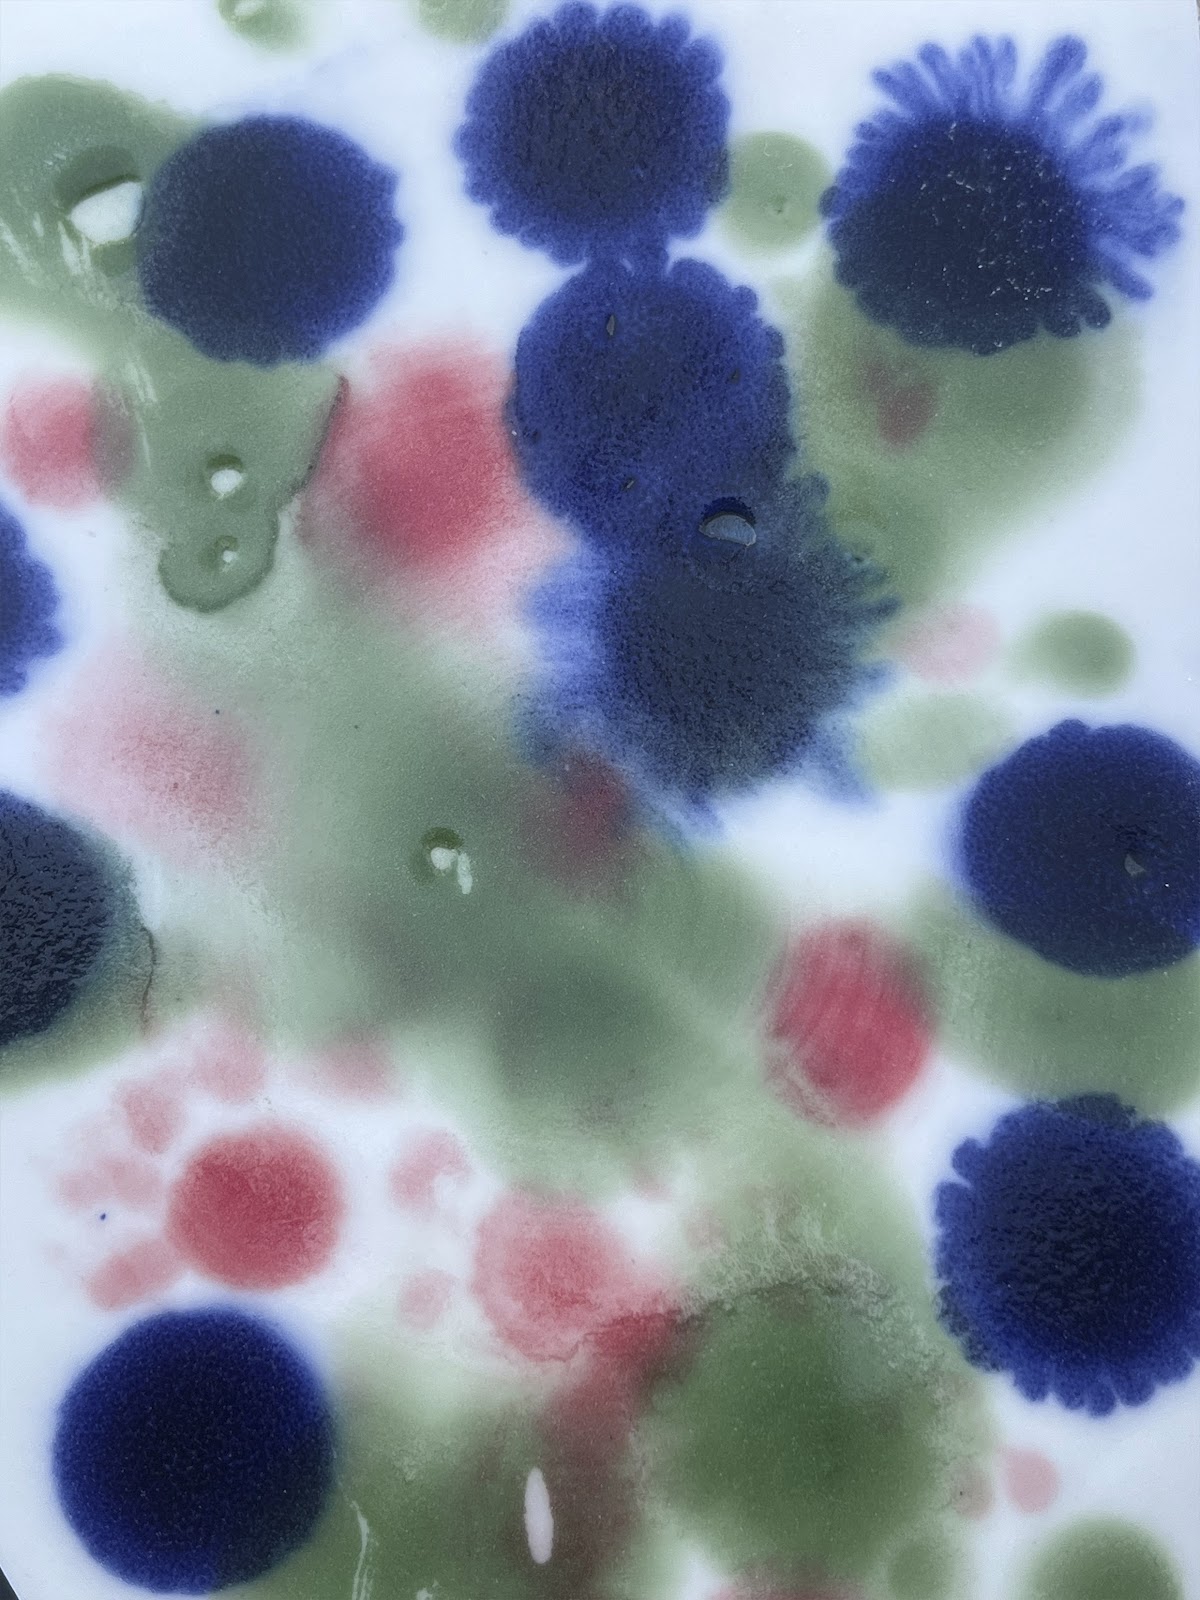

.jpeg)

Esta silla es una exploración realizada a partir de desperdicio que se genera en la industria de la construcción. La premisa es usar el desperdicio como materia prima para la fabricación de mobiliario de la construcción en cuestión. La silla Félix esta fabricada a partir del “Upcycling” de las bolsas de cemento una vez que éstas cumplieron con su función original.
Ocultar semblanzaVer semblanza



Además de presentar "El Tesoro de la Ardilla" y realizar lecturas, incluir una escultura viviente al aire libre de una ardilla simpática que capte la atención de todos los niños. Esta divertida ardilla será interactiva, permitiendo que las infancias se acerquen, la toquen y participen activamente en el cuidado de su entorno. Con el tiempo, podrán ver cómo el pasto y las plantas crecen a su alrededor, mientras aprenden sobre la importancia de la germinación y el cuidado del medio ambiente.
Ocultar semblanzaVer semblanza


Mesa ocasional de altura ajustable hecha con un pedazo de pavimento de la carretera en el Parque Ecológico "La Huasteca", NL, producto de la destrucción ocasionada por el huracán Alberto en 2024.
Algo Studio: diseño contemporáneo con raíz artesanal Fundado en Monterrey en 2019 por Diego Garza —arquitecto con una Maestría en Bellas Artes en Mobiliario por Rhode Island School of Design (RISD)—, Algo Studio es un espacio dedicado al diseño de mobiliario, iluminación y objetos utilitarios que exploran el equilibrio entre la investigación conceptual y la práctica artesanal. El estudio trabaja a partir de la experimentación y el hacer manual, integrando procesos de taller que permiten un control minucioso de cada pieza. Su lenguaje visual se caracteriza por la sencillez de las formas, la riqueza de las texturas y una paleta cromática cálida. Influenciado por el movimiento Memphis, Algo Studio incorpora elementos lúdicos y gráficos, sin perder de vista la funcionalidad y la accesibilidad. Su producción en series pequeñas mantiene cada proyecto en constante evolución. Entre sus colecciones destacan Primitivo Doméstico (Inédito 2020) y Fantástico Primitivo (Salón Cosa 2022), propuestas que reflexionan sobre lo elemental, lo simbólico y lo cotidiano desde una perspectiva contemporánea. En 2024, el estudio abrió una nueva línea de trabajo escultórico con piedra de río, transformada en objetos utilitarios de carácter primitivo y enigmático. Más allá de la función, Algo Studio busca crear piezas que generen experiencias visuales y sensoriales, aportando calidez y significado a los espacios que habitan.
Ocultar semblanzaVer semblanza




Cerámica utilitaria de alta temperatura.
aaba es una marca mexicana nacida en 2020 que diseña y produce cerámica utilitaria contemporánea. Hacemos piezas prácticas e intuitivas, pensadas para ser funcionales y agradables a la vista, poniendo énfasis en la forma de producción para evitar generar desperdicio, optimizar recursos y minimizar el impacto ambiental de cada pieza. Nuestros productos se desarrollan en nuestro taller en el estado de Morelos, con un equipo comprometido y experimentado. Trabajamos con cerámica de alta temperatura (1200 °C), lo que garantiza resistencia y seguridad para uso alimenticio. Todos los esmaltes han sido cuidadosamente desarrollados para lograr los tonos, brillos y texturas que nos distinguen.
Ocultar semblanzaVer semblanza




Jacinto Galería Viva es un estudio de diseño fundado en 2016 por Augusto Herrera en Ciudad de México, nuestro trabajo se centra en la creación de macetas y objetos decorativos que integran la Botánica como como parte esencial y central del diseño. Cada pieza se produce a mano en talleres locales utilizando siempre materiales de la región como el mármol, piedra volcánica, latón y vidrio soplado. En Jacinto Galeria Viva buscamos el equilibrio entre la estética y el uso proponiendo objetos que enmarcan las especies botánicas como elementos centrales del espacio, resaltando la importancia de la naturaleza dentro del entorno construido y promoviendo la integración de la botánica como objeto vivo de deseo y conexión con la naturaleza en nuestra vida cotidiana.
Augusto Herrera (ciudad de Mexico, 1984) Es diseñador y fundador de Jacinto Galería Viva, estudio que fusiona la botánica y eel diseño, su relación con las plantas comenzó en la infancia y lo llevo a fundar en 2016 Jacinto Galería Viva para crear piezas que elevaran la botánica con macetas y objetos de diseño a nuevos lugares dentro de los espacios que habitamos. Jacinto ha participado en diferentes foros de diseño como design week Mexico, design house y desde 2019 creó Casa botánica un espacio que reúne artistas, diseñadores y productores de plantas consolidando un puto de encuentro para los amantes de las plantas en Mexico.
Ocultar semblanzaVer semblanza




En Puercomonte creemos en la importancia del entendimiento cultural para el avance social y en el potencial del juego para el desarrollo humano. Diseñamos y producimos 100% en México con consciencia humana y ambiental: - Impulsamos la integración de artistas y artesanos en el proceso creativo y productivo. - Priorizamos el uso de materiales locales y de bajo impacto ambiental, como la tela o el cartón - Fomentamos la exploración y valoración de tradiciones y lugares únicos en el país mediante el juego. Asimismo, diseñamos para el desarrollo. En nuestros más de 12 juegos impulsamos el desarrollo de habilidades para la vida (como la creatividad o el trabajo en equipo) y brindamos oportunidades para reconectar con el entorno y fortalecer la conexión humana.
Puercomonte es una marca 100% mexicana dedicada al diseño de juegos y juguetes de mano que combinan ingenio y tradición. Su propuesta busca explorar la cultura mexicana en familia y reconectar con lugares, artistas y tradiciones únicas del país, a través de juegos producidos localmente. Diseñados con consciencia humana, los productos de Puercomonte resultan de un esfuerzo colaborativo entre diseñadores, artesanos y productores locales, llevando a los usuarios la esencia de México y enalteciendo el ingenio nacional. La marca ofrece tanto una línea personalizable como la posibilidad de desarrollar juegos a medida en colaboración con sus creativos, consolidando una propuesta que fusiona cultura, diversión y aprendizaje.
Ocultar semblanzaVer semblanza




En WÓOLIS, el mármol es concebido como un testigo del tiempo. Siempre que es posible, se recuperan fragmentos y excedentes para transformarlos en piezas que trascienden su origen material. Cada etapa, desde el corte hasta el pulido, se realiza con respeto hacia la materia, buscando resaltar su memoria geológica y convertirla en presencia contemporánea. Sus creaciones habitan la frontera entre objeto y arte: un tránsito de materia a obra, donde la geometría se convierte en narrativa y la forma conserva la huella de su origen. Cada pieza propone un diálogo entre lo funcional y lo simbólico, entre lo que fue y lo que permanece.
WÓOLIS surge de un diálogo íntimo con la piedra, no como un objeto de lujo, sino como memoria: fragmentos de mármol que alguna vez fueron descartados encuentran en sus manos la oportunidad de transformarse en geometrías nuevas, en cuerpos que habitan los espacios como esculturas vivas. Cada pieza es un acto de respeto hacia la materia y hacia el tiempo que la formó. En el mármol se revelan vetas que funcionan como cicatrices y paisajes, huellas de una tierra que no olvida. El trabajo de WÓOLIS no busca forzar la piedra, sino escucharla y acompañar su voz, para convertirla en arte funcional y en arquitectura a pequeña escala. WÓOLIS representa un puente entre lo que parecía residuo y lo que ahora es permanencia: un taller de memorias que se vuelven presentes, donde la materia se transforma en poesía tangible.
Ocultar semblanzaVer semblanza




Se trata de una mesa de estructura sólida, ensamblada sin herrajes y fabricable con maderas locales y triplay industrial. Diseñada para ser funcional, flexible y accesible, ofrece seis espacios destinados a usos diversos. Su proceso optimiza materiales al obtener ambas cubiertas de un solo panel y permite su construcción con conocimientos básicos de carpintería, adaptándose a distintos contextos, necesidades y gustos. El diseño busca generar un objeto bello, útil y duradero, fácilmente replicable, que habite un espacio intermedio entre la producción en masa y el diseño inaccesible: una propuesta que pone la calidad y el buen diseño al alcance de más personas, sin renunciar a la estética ni a la ética.
Ruy Berumen es arquitecto por la Universidad Iberoamericana. Su formación se enriqueció con intercambios en EMBT, Barcelona, y Sci-Arc, Los Ángeles, experiencias que definieron su aproximación crítica al espacio. Ha colaborado con CHA:COL, Frida Escobedo y PRODUCTORA en Ciudad de México, participando en proyectos reconocidos a nivel nacional e internacional. En 2021 fue seleccionado por el Sistema Nacional de Jóvenes Creadores con Arqueología de asfalto y concreto, explorando el paisaje urbano contemporáneo. Actualmente desarrolla una práctica independiente que abarca distintas escalas: maquetas, mobiliario, instalaciones, arquitectura y estructuras urbanas. Su trabajo se basa en la colaboración, la interdisciplinariedad y la búsqueda de belleza, claridad y sensibilidad hacia cada contexto.
Ocultar semblanzaVer semblanza



Futuros Gastronómicos Gentrificados explora el impacto de la gentrificación en la comida corrida y la estética de la alcaldía Cuauhtémoc (CDMX) a través de objetos especulativos. Tras tres años de investigación y talleres de mapeo colectivo con vecinos y población flotante, se desarrollaron dos piezas que representan futuros opuestos. Plato Atrio, elaborado a mano en cerámica con formas orgánicas, invita a compartir entre más de tres personas y plantea enfrentar la gentrificación desde la mesa como un espacio comunitario. En contraste, Plato AC1C, impreso en 3D con geometrías angulares y materiales plásticos, refleja un futuro de no-lugares y “no comida”, donde la gentrificación genera aislamiento mediado por la tecnología. Ambas piezas materializan la tensión entre comunidad y soledad en contextos gentrificados, proponiendo una reflexión sobre los cambios sociales, culturales y urbanos que afectan la vida cotidiana.
Majo Villa Design Research Studio Majo Villa Design Research Studio concibe el diseño como un método y un medio para investigar, interpretar y narrar aquello que atraviesa lo personal y lo común. El estudio combina investigación antropológica y sensorial con narrativas sociales para explorar lo sensible en la comida, la vida urbana y la cultura material. A través de talleres, objetos y relatos, convierte sus hallazgos en formas tangibles que invitan a la reflexión y al diálogo. El estudio habita un territorio intermedio entre lo cotidiano y lo especulativo, lo urbano y lo íntimo, diseñando a partir de preguntas, contando historias mediante objetos e imaginando futuros posibles.
Ocultar semblanzaVer semblanza




Piedra Santa es una marca fundada por artistas, arquitectos y diseñadores que transforma fragmentos de piedra: mármoles, granitos, cuarzos, travertinos, entre otros, en objetos decorativos, mobiliario y recubrimientos para muros que combinan arte, diseño y funcionalidad. Su proceso se basa en la economía circular: seleccionan materiales reutilizables, los reconfiguran y prolongan su ciclo de vida mediante un modelo de negocio flexible que contempla venta, renta y leasing. Cada pieza cuenta una historia de permanencia y transformación. Su primera colección, Tramonto, está conformada por luminarias empotrables capaces de adoptar formas orgánicas, redondas o cuadradas, adaptándose a distintos espacios y necesidades bajo una misma premisa: diseñar objetos que no se desechan, sino que evolucionan.
Piedra Santa es un estudio fundado por artistas, arquitectos y diseñadores que explora la relación entre materialidad, función y narrativa. A partir de fragmentos de piedra —mármoles, granitos, cuarzos y travertinos— desarrolla objetos decorativos, mobiliario y recubrimientos para proyectos de interiorismo y arquitectura, trabajando bajo principios de economía circular y aprovechamiento consciente de recursos. Su trabajo busca trascender modas, proponiendo piezas que evolucionan y permanecen. Como primera colección presenta Tramonto, un arte objeto compuesto por luminarias contemplativas y empotrables capaces de adoptar diversas formas y configuraciones. El equipo de Piedra Santa está integrado por artesanos y diseñadores con formación en arquitectura, diseño e ingeniería de producto, así como experiencia en interiorismo, mobiliario e iluminación. Su filosofía parte de una convicción clara: el diseño no se desecha, se transforma.
Ocultar semblanzaVer semblanza




Suljaa’ es un mobiliario escolar para que niños indígenas de Guerrero puedan aprender dos idiomas. Es diseño al servicio de la educación. Es un proyecto que contribuye al modelo pedagógico denominado 50-50 Guerrero, donde la infancia de la región amuzga aprende ñomndaa’ (amuzgo) y español de manera simultanea, en la escuela primaria. Este plan pedagógico necesita atmósferas que fomenten la interculturalidad por lo que se reconoció al mobiliario como un detonante del aprendizaje, al plasmar aspectos de su cultura, como algunas de sus iconografías más representativas. En las sillas, los artesanos amuzgos — al igual que en las vestimentas de la región— tejen montañas, insectos de agua, pájaros, flores y más elementos que forman parte del alfabeto amuzgo o ñomndaa’.
RAMSES VIAZCAN ESTUDIO se especializa en crear productos innovadores que combinan a la perfección funcionalidad y estética preservando la rica cultura y tradición de México. Si bien la experiencia del estudio se basa en la conceptualización y ejecución de proyectos de mobiliario y producto, también explora otros campos, como el diseño gráfico y de interiores. Con un profundo aprecio por la herencia mexicana, el estudio del diseñador mexicano Ramses Viazcán busca infundir elementos de la cultura y tradición local en sus diseños, ofreciendo soluciones versátiles y atractivas que honran la diversa historia del país y al mismo tiempo satisfacen las demandas de la vida contemporánea.
Ocultar semblanzaVer semblanza

Platos experimentales En estos platos, la decoración se concibe como un campo de prueba donde el color no es una verdad estable, sino una relación en tránsito. Su manifestación está siempre condicionada por el contraste, el soporte y el contexto; nunca actúa de manera autónoma. La experimentación no busca establecer una paleta definitiva, sino permitir que cada intervención dialogue con la porcelana, con la luz y con los accidentes del proceso. Estos objetos registran una investigación sobre cómo se transforma el sentido del color al aplicarse sobre un material tan radicalmente blanco y exigente, que obliga a percibir cada matiz como si fuera nuevo.
Cacharro Muciño Cacharro Muciño es un estudio mexicano dedicado a la experimentación y producción de porcelana utilitaria. Fundado en 2018 tras años de investigación sobre pastas cerámicas, combina rigor técnico con exploración estética para crear piezas de gran blancura y translucidez. Sus colecciones incluyen vasos, platos y objetos de iluminación, concebidos como artefactos cotidianos que revelan el valor del proceso manual. Cada pieza surge del equilibrio entre diseño, error y hallazgo, entendiendo la porcelana no solo como un material, sino como un campo de ensayo para descubrir nuevas formas de habitar lo utilitario.
Ocultar semblanzaVer semblanza




Laboratorio de Puntadas es un proyecto de exploración textil que metodiza el error como detonante de innovación formal y material. Cada portamaceta es un espécimen único, resultado de experimentar con la tensión y la estructura de la puntada en fibras naturales de origen vegetal y animal, tejidas sobre un soporte rígido que define su forma escultórica. Este proceso de creación, lento y artesanal, trasciende la decoración para proponer piezas de autor donde lo imperfecto deviene en la máxima expresión de valor estético y conceptual. Son objetos que dialogan con el espacio arquitectónico desde la textura, el cuerpo y la morfología orgánica.
MANÍ ARTE | Creación Textil es un proyecto dedicado a revalorizar los saberes textiles artesanales. Se propone fusionar la herencia de las técnicas de tejido en bastidor —con un profundo respeto por el legado matérico femenino— con el lenguaje del diseño contemporáneo. A través de un proceso de experimentación, transforma fibras naturales en piezas únicas y escultóricas que buscan habitar e intervenir el espacio, dialogando con la arquitectura desde la textura, la memoria y la forma orgánica.
Ocultar semblanzaVer semblanza




Colección Comfort nace con la intención de devolver comodidad y dignidad al espacio público. Se trata de una línea de mobiliario urbano que combina la geometría limpia de la estructura de acero con el eco-rubber, material elaborado a partir de llantas recicladas. El resultado equilibra resistencia y suavidad, solidez y flexibilidad. Las superficies amortiguan y suavizan la experiencia de sentarse, transformando los desechos de la movilidad en lugares de descanso donde detenerse y compartir. Cada pieza ofrece comodidad y una ligera flexión al usarse, alejándose de la rigidez habitual y explorando la posibilidad de acoger y de cuidar. La colección propone un gesto simbólico: reconvertir la huella de la ciudad. Como la maleza, surge en la adversidad y resiste, recordando que la comodidad en el espacio público es un derecho colectivo.
Peek es un estudio de diseño especializado en la creación de mobiliario urbano creativo, sorprendente y original para los espacios públicos. Su equipo fundador cuenta con más de veinte años de experiencia colaborando con arquitectos, arquitectos paisajistas, urbanistas y agencias de gobierno en proyectos que han transformado el espacio público en México, y cuyo trabajo ha sido reconocido con premios nacionales e internacionales. El compromiso de Peek es diseñar mobiliario para espacios dignos, funcionales y vibrantes, donde las personas puedan convivir y disfrutar. Convencido del poder transformador del diseño, el estudio busca dejar una huella positiva y contribuir a la construcción de ciudades con entornos más humanos y accesibles, donde el mobiliario urbano no solo ocupe espacio, sino que lo enriquezca. Integrantes: Karime Tosca, Daniel Olvera, David Valladares, José Luis [apellido], Ariadna Reyes, Bruno Dávila y Victoria Orozco. peek.design | diseño alrededor
Ocultar semblanzaVer semblanza




Laelia Biodiseño es un laboratorio ubicado al sur de la Ciudad de México, dedicado a la investigación y creación de biomateriales a partir de residuos orgánicos y vegetales locales. Su proceso combina experimentación científica, diseño colaborativo y saberes tradicionales, transformando flores como el cempasúchil, fibras, cactáceas y restos agroindustriales en biotextiles, bioresinas, biopolímeros y pigmentos. El estudio se centra en generar alternativas sostenibles para el arte, el diseño y la moda, proponiendo materiales funcionales y accesibles que sustituyen a los sintéticos sin perder valor estético. Cada pieza es el resultado de una investigación orientada a la innovación y a prácticas sustentables.
Judith CovaSau (1992) es una bioartista, investigadora y docente mexicana especializada en biomateriales aplicados al arte y el diseño. Egresó con Mención Honorífica del Posgrado en Artes y Diseño de la UNAM, donde inició una producción escultórica basada en elementos orgánicos y el método científico. Su trabajo explora plantas, pigmentos naturales y motivos botánicos. Ha expuesto en México, Chile, Colombia, India y Argentina, en instituciones como la Universidad Austral de Chile, Universidad de Medellín, Universidad Somaiya Vidyavihar, Antigua Academia de San Carlos y Cromática Galería. Fue beneficiaria del programa “Contigo en la Distancia” (2020), impartió talleres internacionales en India (2021, 2023) y participó en muestras como Ecotono y Biopolimérica. Su proyecto Mexcalxóchitl fue seleccionado para Biopolimérica 2025 e incluido en el catálogo 24|25 del Mapeo de Abundancias Latinoamericanas. Actualmente es profesora de arte y biomateriales en la Universidad de la Comunicación y en CENTRO.
Ocultar semblanzaVer semblanza




FRAGMENTOS combina mármol y vidrio en un equilibrio artesanal donde lo frágil también sostiene. Elaboradas por escultores de mármol y sopladores de vidrio de la región, las piezas celebran oficios tradicionales y procesos 100% artesanales, adaptados a un lenguaje contemporáneo. La unión de estos materiales opuestos se convierte en un acto de experimentación, resiliencia y empatía, revelando cómo la fragilidad puede soportar peso y significado. Más que objetos, FRAGMENTOS funciona como un manifiesto que invita a repensar el diseño como memoria, resistencia y conexión humana en tiempos de transformación.
Jazo Romero es diseñador y fundador del estudio Jazo Romero Mexican Exclusive Design, cuya práctica habita el cruce entre arte, diseño y artesanía. Su obra enlaza la memoria de los procesos tradicionales mexicanos con materiales y técnicas contemporáneas, dando vida a piezas que oscilan entre lo frágil y lo sólido, lo experimental y lo funcional. Ha llevado su visión a escenarios internacionales como Italia, Nueva York, Design Week México y London Design Festival, consolidando una práctica que concibe el diseño como un acto de memoria, resiliencia y conexión humana. Desde Monterrey, su estudio impulsa diálogos con artesanos y desarrolla proyectos que celebran la materia como un lenguaje poético y transformador.
Ocultar semblanzaVer semblanza




Características La lámpara está conformada por tres partes principales: un cable de 1.5 m de longitud con dimmer integrado para controlar la intensidad de la luz; una base que funciona como enlace entre el cable y la bombilla; y una pantalla cilíndrica que dispersa la luz en el espacio donde se coloca. La base está recubierta con una lámina de aluminio inoxidable, cuya función es reflejar el entorno en su superficie y aportar una sensación de ligereza al diseño. Proceso La pantalla y la base se desarrollan mediante diseño paramétrico utilizando las herramientas de modelado Rhino Ceros y Grasshopper. Posteriormente, se materializan a través de impresión 3D con filamento reciclado en color blanco. Materiales Cable textil calibre 18 con atenuador de luz tipo perilla. Base: pieza impresa en 3D con filamento reciclado, recubierta con lámina de aluminio calibre 22. Pantalla: pieza impresa en 3D con filamento reciclado (11 cm x 24 cm), acompañada de un foco LED E27.
Oku Lamp es un taller de diseño especializado en la creación de lámparas escultóricas y únicas, concebidas para materializar formas complejas y funcionales a partir de métodos tradicionales de producción. Su proceso creativo inicia en Grasshopper, un lenguaje de diseño algorítmico que permite explorar formas orgánicas, geométricas y fluidas. Este enfoque optimiza los procesos de fabricación, genera patrones y mallas complejas capaces de manipular la luz de manera dinámica, creando juegos de sombras y atmósferas, y brinda la posibilidad de personalizar los diseños según diferentes escalas o requerimientos específicos mediante el ajuste de parámetros. Las piezas se producen mediante impresión 3D, utilizando filamento reciclado de alta calidad que asegura durabilidad y un acabado excepcional. El trabajo de Oku Lamp demuestra cómo la interacción entre algoritmos, diseño y métodos de producción tradicionales puede dar origen a objetos de iluminación de alta calidad, funcionales y accesibles para todo tipo de público.
Ocultar semblanzaVer semblanza




La serie Ermita de OCUO se compone de luminarias que exploran la relación entre materia y atmósfera a través de la luz. Cada pieza está elaborada con piedra volcánica, trabajados de manera artesanal para generar volúmenes sobrios y atemporales, complementados con detalles de latón y difusores de luz en vidrio soplado. El proceso constructivo combina técnicas manuales de tallado y fundición con acabados de precisión, resaltando la textura y densidad de los materiales. En la exposición se presentan dos arbotantes de muro (Ø12 cm), dos lámparas de mesa (Ø22 cm × 30 cm) y una lámpara de piso (Ø22 cm × 110 cm), todas con fuente LED de 24 W, diseñadas para crear atmósferas íntimas mediante un juego de luces y sombras.
OCUO es un estudio de diseño mexicano fundado por Iñigo Artigas, arquitecto, y Bernardo Noriega, diseñador digital. Amigos desde la infancia, siempre compartieron el deseo de crear un estudio que transformara los espacios a través de la luz. Sus visiones una desde lo físico y otra desde lo digital, se complementan para dar forma a un enfoque único. El estudio explora la relación entre materia, luz y espacio mediante objetos de alto valor estético y funcional. Su trabajo se centra en la experimentación con materiales naturales como la piedra volcánica, el latón y el vidrio soplado, dando lugar a piezas que trascienden lo utilitario para convertirse en objetos de contemplación. Con un proceso artesanal contemporáneo y una manufactura cuidada, OCUO busca generar obras que transmitan identidad, permanencia y una visión experimental del diseño en México
Ocultar semblanzaVer semblanza




5 Piezas de Mobiliario, 1 silla de 50.00x70.00x85.00cm de Madera de encino de 1.25" Tintada al alcohol, con acabado en aceite natural. 1 Perchero Vertical de 175.00x33.00x10.00cm, de madera de encino de 1.25" con acabado en aceite natural, 1 Mesa Auxiliar de 25.00x25.00x60.00cm de madera de encino de 1", Tintada al alcohol, con acabado en aceite natural, 1 Lampara de escritorio de 20.00x20.00x40.00cm de madera de encino, Tintada al alcohol, con acabado en aceite natural, Mesa de Centro de 80.00x80.00x40.00cm de madera de encino en la cubierta y patas de ceramica.
La Moderna es un estudio conformado por tres diseñadores que creen en el poder de los oficios como agentes de cambio. El colectivo decidió abrazar la carpintería para desarrollar habilidades que les permitan materializar sus ideas y continuar evolucionando como diseñadores. El nombre del taller rinde homenaje al barrio de La Moderna en Monterrey, donde se encuentra su espacio de trabajo. Este barrio está lleno de pequeños talleres de diversos oficios que han sobrevivido durante años, y el estudio se concibe como un tributo a quienes han estado antes, así como un piso firme para futuros proyectos. Como diseñadores jóvenes, también reconocen la dificultad de encontrar talleres que abran sus puertas para desarrollar proyectos propios, lo que motivó la creación de La Moderna, ofreciendo un espacio accesible para otros diseñadores emergentes y fomentando alianzas que permitan crecer de manera conjunta.
Ocultar semblanzaVer semblanza




Vajilla de cerámica de alta temperatura, elaborada a mano mediante el proceso de vaciado cerámico, lo que asegura repetición en las formas y resistencia en el uso cotidiano. Inspirada en los rituales culinarios reconocidos por la UNESCO como Patrimonio Cultural Inmaterial de la Humanidad, esta colección busca rendir homenaje a la comida como lenguaje universal y vínculo entre comunidades. El proyecto consta de 5 piezas que conforman una familia de objetos cohesionada bajo un mismo planteamiento estético. El elemento toroidal funciona como recurso formal recurrente que se repite con variaciones en cada pieza, creando una unidad visual y conceptual.
MOT es un estudio de diseño de producto que crea objetos atemporales y de alto detalle para la vida cotidiana, enalteciendo cada pieza y otorgándole la importancia que merece. Su inspiración nace de la posibilidad de hacer especial cada día. Las piezas desarrolladas por el estudio están concebidas para integrarse a la vida de quienes las poseen, transformando los espacios en refugios de comodidad y expresión personal. Convencidos de que ningún objeto es común y que cada detalle cuenta, en MOT diseñan con pasión, honestidad y creatividad, ofreciendo objetos que permanecen con significado, acompañando el día a día de manera duradera y significativa.
Ocultar semblanzaVer semblanza




Colección de esculturas lumínicas desarrollada con pantallas traslúcidas hechas en PETG y aluminio. El resultado es una pieza que acompaña al usuario a través del espacio, sumergiéndolo en una experiencia visual que busca romper la cotidianeidad y exaltar los sentidos. La colección está compuesta por 4 luminarias que buscan desafiar la geometría clásica, exponiendo sin reservas sus procesos y ensambles. La crudeza de los materiales redefine la experiencia de revelar, mirar y experimentar la luz.
Nuumbra Estudio Nuumbra Estudio es un taller multidisciplinario de diseño y producción luminotécnica fundado en 2020 en la Ciudad de México. Su práctica conjuga la arquitectura, el diseño de iluminación y la escenografía con el objetivo de crear experiencias sensoriales a partir de la luz y la sombra, bajo el concepto diseño + fabricación. La visión de Nuumbra busca explorar el lenguaje de la luz desde distintas ópticas y disciplinas, proponiendo enfoques innovadores y experimentales.
Ocultar semblanzaVer semblanza




Gatiwis es una colección de mobiliario y objetos para los verdaderos dueños del hogar contemporáneo. La primera colección consta de steps, árboles, camas y bosques enteros para que tu gatiwis tenga los espacios que siempre ha merecido, y para que tú vivas rodeado de más objetos coloridos, bellos y funcionales. Gatiwis diseña estratégicamente sus piezas para ser resistentes, modulares y seguros. Nos importa generar el menor desperdicio posible, por lo nuestros muebles están hechos con la mejor madera, para durar. Los módulos suaves (cojines, rascadores y colchones) están hechos con materiales que dan gran batalla a las uñas de tu gatiwis, con repuestos que llegan hasta la puerta de tu casa de forma accesible. Abajo los malos muebles para gatos, mejor Gatiwis.
It’s Tomorrow! es un estudio independiente de diseño estratégico con sede en la Ciudad de México, fundado en 2025 por Diego Olguín, diseñador con 11 años de experiencia que regresó a México tras completar una maestría en la Harvard University Graduate School of Design y trabajar durante dos años en la ciudad de Nueva York. El estudio se especializa en branding y desarrollo de productos, atendiendo a una audiencia global. Su enfoque consiste en crear marcas e ideas que aporten color, emoción y valor positivo al mundo. Gatiwis, una marca propia desarrollada por el estudio, funciona como ejemplo de sus capacidades: desde la estrategia y el branding hasta el diseño de productos, mostrando cómo It’s Tomorrow! puede atender audiencias específicas mediante diseño estratégico, siempre con un enfoque creativo y dinámico.
Ocultar semblanzaVer semblanza




En TONTON, todas las piezas se elaboran desde cero. El proceso inicia con la adquisición de arcilla a un pequeño proveedor local en las afueras de Puebla, seguida de la preparación de la mezcla cerámica según la fórmula propia del estudio, que luego se vierte en moldes de yeso elaborados a partir de modelos impresos en 3D. Una vez listas las piezas, se procede a la fase de postproducción, corrigiendo imperfecciones para garantizar calidad. Tras una semana de secado, las piezas se cuecen y, posteriormente, se sumergen en esmaltes preparados con fórmulas propias. Finalmente, se corrigen posibles imperfecciones generadas por el esmalte antes de la quema final, dejando las piezas listas para su venta. Todas las piezas son diseñadas, elaboradas y comercializadas por los dos fundadores del estudio, reflejando la esencia de los creadores; cada objeto conserva una parte de su humanidad y cercanía, haciendo que cada pieza sea única.
Tonton busca incorporar el humor en el diseño de manera literal. La marca surge con el objetivo de salir de lo convencional de forma divertida; cada producto cuenta una historia, acompañada de la personalidad de Tontin & Tonton. Cada pieza es única, no responde a estilos, tendencias ni modas, y no pretende vender por vender ni ser algo que no es; su propósito principal es provocar una sonrisa en quienes las observan. Tonton representa un diseño sin restricciones, sin intención de complacer a nadie, explorando y experimentando con la creatividad de sus creadores. La marca se centra en “diseñar para uno mismo”, liberando un sentimiento de creatividad reprimida. Tonton produce objetos domésticos en cerámica de alta calidad, siguiendo su propio camino. Adopta la torpeza e inmadurez como atributos distintivos, reconociendo que no es perfecto y que su recorrido creativo apenas comienza.
Ocultar semblanzaVer semblanza




Línea Cero es una investigación formal que explora la repetición modular del tubo metálico como gesto arquitectónico y escultórico. La silla y la mesa que integran esta serie se construyen a partir de tubo de lámina negra calibre 16 (Ø 19 mm), rolado con radios de 50 mm, soldado y terminado en pintura electrostática. La mesa incorpora una cubierta de vidrio templado de 6 mm, generando una tensión entre lo sólido y lo etéreo. Más que mobiliario, la colección invita a reflexionar sobre el vacío, la transparencia y la continuidad de la línea en el espacio, articulando ergonomía y rigor estructural en un lenguaje minimalista e industrial, concebido para entornos residenciales, culturales y comerciales.
Diego Alcántara Silva es un diseñador mexicano cuya práctica se centra en la intersección entre funcionalidad, estética y contexto. Su trabajo explora el mobiliario como un medio de experimentación formal, creando piezas que equilibran ergonomía, durabilidad y un lenguaje sobrio con influencias minimalistas e industriales. Interesado en el impacto del diseño en la vida cotidiana, desarrolla proyectos que investigan materiales, procesos productivos y narrativas espaciales. Actualmente dirige Da.studio, un estudio en consolidación que busca posicionarse dentro de la escena del diseño contemporáneo en México, donde cada pieza funciona como un manifiesto estético y conceptual
Ocultar semblanzaVer semblanza


Silla periquera hecha de madera de pino con herrería de acero, diseñada y elaborada para bar Anzuelo en Puerto Escondido, Oaxaca.
Taller TAS es un despacho de diseño e ingeniería, ubicado en la CDMX y Puerto Escondido, que busca proponer soluciones que tomen en cuenta el contexto, la función y sus consecuencias estéticas.
Ocultar semblanzaVer semblanza




El conjunto está compuesto por la silla Kulen’, la lámpara Misbah y la mesa lateral Óox, piezas que comparten la fabricación artesanal mediante ensambles. La silla Kulen’, cuyo nombre en maya significa “sentarse”, está elaborada en madera de tzalam con botones de encino y asiento tejido en fibras. Su diseño desmontable incorpora ensambles de caja y espiga ocultos, optimizando transporte y almacenamiento, al mismo tiempo que conserva la ergonomía necesaria para la lectura o el descanso. La lámpara Misbah, que en árabe significa “luz”, proyecta iluminación a través de una celosía en tzalam, sostenida por una estructura y cajón de triplay de sande. La mesa lateral Óox, también en tzalam, emplea ensambles de caja y espiga, completando un conjunto que fusiona tradición artesanal con diseño contemporáneo.
Alejandro Vidal Ruiz es arquitecto y diseñador, especializado en la creación de mobiliario contemporáneo con raíz artesanal. Su trabajo parte del dominio de la carpintería y la ebanistería, desarrollando piezas que se destacan por su precisión constructiva, el cuidado en los ensambles y el uso de maderas locales como el tzalam. Fundador del estudio Trotamundo Wood & Design, ha impulsado proyectos que integran tradición y modernidad, explorando tanto la escala doméstica como la colectiva del objeto. Su obra ha sido presentada en el Abierto Mexicano de Diseño, DIMUEBLE y en plataformas internacionales como Wanted Design/ICFF en Nueva York, consolidando una práctica que enlaza cultura material e innovación.
Ocultar semblanzaVer semblanza




La producción comienza con la recolección de merma de cobre, que se funde para generar bloques en bruto. Posteriormente, los bloques se rolan hasta obtener el calibre deseado. Todo el proceso es realizado de manera artesanal por maestros de Santa Clara del Cobre, Michoacán, con quienes se han desarrollado técnicas únicas para elaborar distintos acabados, formas y texturas. La luminaria Rivarno está confeccionada en lámina de cobre calibre 18, con acabado semioxidado al fuego y doblado manualmente; su base, labrada en piedra recinto, funciona como contrapeso y aporta contraste de textura. Cuenta con una tira LED de 2700 K, voltaje de 110–120 VAC y consumo de 7 W. La mesa de centro Masso es un monolito de lámina de cobre martillado calibre 16, con acabado semioxidado al fuego.
Aura Carpio® es una firma de diseño escultórico contemporáneo que combina testimonio cultural y acción social. Sus piezas exploran el cobre, el mármol y otros elementos de diversas regiones de México, cuestionando la función del diseño para comprender al individuo y su colectividad. La combinación de técnicas tradicionales y contemporáneas da origen a su obra.
Ocultar semblanzaVer semblanza